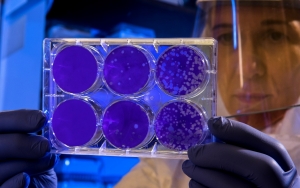
Κορονοϊός: Αρνητικά όλα τα δείγματα που εστάλησαν από την Κεφαλονιά τις προηγούμενες ημέρες

Βόλος: Συνελήφθη 56χρονος που καταδίωκε τον... Κορονοϊό!
Αφού του επιβλήθηκε πρόστιμο ο άνδρας αναχώρησε για την Αθήνα όπου εντοπίστηκε και οδηγήθηκε σε ψυχιατρείο
Κορονοϊός: Ξεκινούν τεστ κατ’ οίκον από 500 Κινητές Μονάδες Υγείας
Αποτελεί κοινή Υπουργική Απόφαση των υπουργών Οικονομικών, Ανάπτυξης, Υγείας
Ημερομηνία-σταθμός: Η πρόβλεψη του Πανεπιστημίου Κρήτης για το τέλος της πανδημίας στην Ελλάδα
Το ευχάριστο νέο της ημέρας...
Κορονοϊός: Η Κεφαλονιά… "μπάζει" από αέρος!
Και ενώ μόνο οι μόνιμοι κάτοικοι μπορούν πλέον να μπουν στο νησί ακτοπλοϊκώς, από αέρος το σύστημα μοιάζει να είναι… διάτρητο!
Πρόεδρος Τοπικής Κοινότητας Πυργιού: «Μείνετε σε καραντίνα, όσοι ήρθατε σε επαφή με την οικογένεια…»
Η Ανάρτηση του Γεράσιμου Παπαδάτου σε μέσο κοινωνικής δικτύωσης